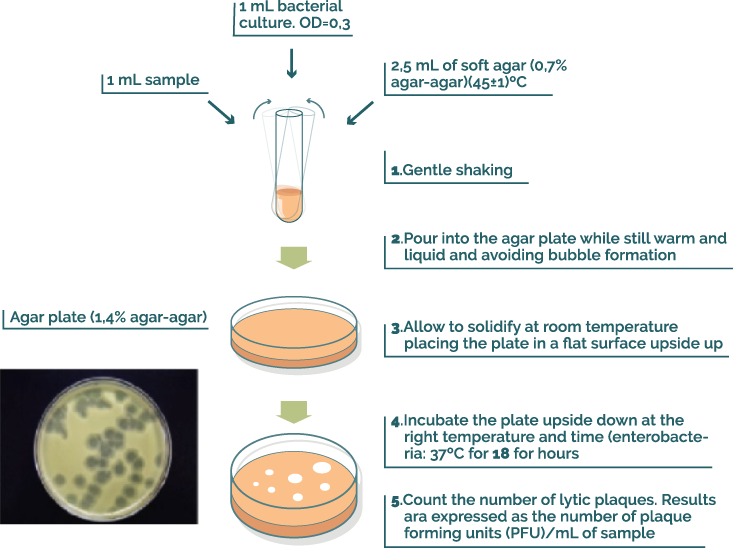

Detection and enumeration methods
Before starting to look at detection and enumeration, we should perhaps talk a little bit about sampling and conservation of the samples. When taking a sample the ideal situation would probably be to do the analyses as soon as possible, but the tests can be delayed, if needed, by 48-72 hours as long as the samples are kept at 4ºC. It is easy to concentrate phages from volumes up to one liter, and small volumes can keep their phage density for months when stored at -20ºC, or -80ºC after adding 10% v/v glycerol.
When working with bacteriophages, we do not need to worry about phenomena such as stress, injury or reactivation that frequently lead to misinterpretation of environmental data on bacterial indicators.
All of the above makes it easy to work with phages as an indicator.
The detection and enumeration of an infectious (living) bacteriophage depends on the fact that they lyse a susceptible host cell.
It is possible to detect the presence of phage genomes or fragments of genome by nucleic acid amplification techniques such as PRC. However, the detection of whole genomes or fragments of genome in a sample does not guarantee that they correspond to phages which are still alive and hence capable of infecting and replicating in a susceptible host cell.
Lysis of a host cell can be detected by visual observation due to the decrease in opacity of a matrix containing the host cells. This can be seen either by the appearance of clear areas in an opaque solid layer of host cells (see figures 1 and 2) or by a decrease in the optical density of a liquid suspension of host cells.
It is also possible to detect host cell lysis by detecting the appearance of an intracellular enzyme in the supernatant that has been released by lysis.
4.1 Methods based on direct observation of host cell lysis
Nowadays, standardized methods for the detection and enumeration of bacteriophages are based on this principle. They can be quantitative methods and presence/absence methods (Adams, 1959).
Quantitative methods are those that allow direct quantification of infectious viral particles in a sample. The number of viruses is visible when making a culture consisting of an agar monolayer containing both bacteria and the sample that may contain bacteriophages. After incubation on a Petri plate, we can observe clear areas of different sizes where turbidity (a typical feature of Petri plates where there is a mass bacterial culture) is lost due to cell destruction. Each clear area (called a plaque) is caused by a bacteriophage (or clump of bacteriophages). When counting, we speak about plaque-forming units (PFUs) instead of saying an absolute number of viruses as it is possible that the virions attach to one another, and thus an agglomerate of more than one bacteriophage can only attack one bacterium. In some literature PFUs can also be called PFPs (plaque-forming particles).
The two main quantitative methods are single agar layer (SAL) and double agar layer (DAL). Both SAL and DAL are based on the appearance of plaques on an agar layer made of semisolid agar, a culture containing the desired bacterial strain, and the problem sample. After incubation overnight the plaques can be observed in the agar plate if there are bacteriophages in the sample. The difference between the two methods is that DAL has an extra solid agar layer under the semisolid one that makes a more stable base for the second layer, which is an advantage in situations where the Petri plates are in a bad state or made of poor quality materials. For the results obtained to be statistically valid, the number of PFUs on a Petri plate has to be between 30 and 300. This is why it is recommendable to make several dilutions of the sample before starting the procedure.

The presence/absence methods are those that, by themselves, only indicate whether or not there are bacteriophages in a given volume of the tested sample. The traditional presence/absence method is the spot test, which consists of putting a drop of a decontaminated aliquot of an enrichment culture on a Petri plate where previously we cultured bacteria. After incubating, the place where the drop was put loses its turbidity due to cell destruction if there are bacteriophages in the sample. The enrichment culture consists of a liquid culture of the host bacteria, inoculated with an aliquot of a sample and incubated for a number of hours.
This kind of method does not allow direct quantification, but the number of infectious viral particles can be determined using quantal (statistics-based) methods. The most used of them is MPN (most probable number) which consists of making presence/absence tests with different amounts (or dilutions) of the sample and making several replicas of each amount (or dilution) of sample to determine, using statistics, the amount of virus in a certain volume of sample. This kind of method increases their sensitivity when increasing the number of replicas performed, until the point that they can be as accurate as quantitative methods.
4.2 Methods based on the determination of molecules released by cell lysis
These methods are based on the discharge of intracellular enzymes to the growth medium when the bacteria lyse. This kind of method requires identifying easy-to-detect intracellular enzymes, such as adenylate kinase and adenosine 5’-triphosphate, β-galactosidase and β- glucuroronidase, for which chromogenic or fluorogenic substrates are available (Guzman et al. 2009, Salter et al., 2010, Muniesa et al., 2018)
At present this procedure is only applicable to liquid suspension and hence for presence/absence determination. However, as explained in the previous section, accurate quantal methods such as most probable number (MPN), can be used.
4.3 Specific methods
Standardized methods
Based on these principles, the following standardized methods are available for bacteriophages proposed or being used as indicators. The key feature of standardized methods is the host bacteria selected for the method.
International Standardization Organization. Water Quality—Detection and Enumeration of Bacteriophages—Part 1: Enumeration of F-specific RNA Bacteriophages; ISO-10705-1; International Standardization Organization: Geneva, Switzerland, 1995.
International Standardization Organization. Water Quality—Detection and Enumeration of Bacteriophages—Part 2: Detection and Enumeration of Somatic Coliphages; ISO-10705-2; International Standardization Organization: Geneva, Switzerland, 2000.
USEPA Office of Water. Method 1601: Male-specific (F+) and Somatic Coliphage in Water by Two-step Enrichment Procedure; EPA 821-R-01-030; USEPA Office of Water: Washington, DC, USA, 2001.
USEPA Office of Water. Method 1601: Male-specific (F+) and Somatic Coliphage in Water by Two-step Enrichment Procedure; EPA 821-R-01-030; USEPA Office of Water: Washington, DC, USA, 2001.
USEPA Office of Water. Method 1602: Male-specific (F+) and Somatic Coliphage in Water by Single Agar Layer (SAL) Procedure; EPA 821-R-01-029; USEPA Office of Water: Washington, DC, USA, 2001.
Rice, E.W.,Baird, R.B., Eaton, A.D. and Clesceri, L.S. Standard Methods for the Examination of Water and Wastewater; American Public Health Association, American Water Works Association, Water Environment Federation. Washington, DC, USA, 2012.
International Standardization Organization. Water Quality—Detection and Enumeration of Bacteriophages-Part 4: Detection and enumeration of bacteriophages infecting Bacteroidesfragilis; ISO-10705-2 International Standardization Organization, Geneva, Switzerland, 2001
Emerging methods
Some emerging detection methods are based on the detection of an enzyme released by cell lysis into the liquid matrix where phage infection of a host cell occurs. These methods appear to be simple, fast, cost-effective and as accessible as user-friendly kits.
BLUEPHAGE is a method based on this principle for which engineered host cells have been designed to increase the specificity, sensitivity and speed of the procedure.
References
Adams, M.H. (1959). Bacteriophages. Interscience Publishers Inc. New York.
Guzmán Luna, C., Costán-Longares, A., Lucena, F. and Jofre, J. Detection of somatic coliphages through a bioluminescence assay measuring phage mediated release of adenylate kinase and adenosine 5’-triphosphate. J. Virol. Methods 2009, 161, 107–113.
Salter, R.S. and Durbin, G.W. Modified USEPA method 1601 to indicate viral contamination of groundwater. J. Am. Water Works Assoc. 2012, 104, 480–488.
Muniesa, M., Ballesté, E., Imamovic, L., Pascula-Benito, M., Toribio-Avedillo, D., Lucena, F.and and Jofre, J. 2018. Bluephage: A rapid method for the detection of somatic coliphages used as indicators of fecal pollution in water. Water Research 128: 10-19.


